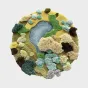
Оригинальный ковёр "Мох" ART Design из молочного шёлка KV39222-32

Оригинальный ковёр "Мох" ART Design из молочного шёлка KV39222-32
Оригинальный ковёр из молочного шёлка с разной длиной ворса, имитирующего мох. Разные формы и размеры ковра позволят подобрать оптимальный размер.
Доставка в пределах и за пределах МКАД, доставка за пределы МКАДа до 20 км, если больше — то следует выбрать доставку в регионы России
Вы сможете самостоятельно забрать ваш заказ в нашем салоне на следующий день После заказа в том случае если заказ Был осуществлён до 11:00
Пункт выдачи заказов находится в 10 минутах от метро Саларьево по адресу г. Москва, квартал № 32, вл16 с2, БЦ Neopolis, 3 этаж. Перед выездом сообщить о приезде.
Так же вы можете заказать набор товара в любом из офисов выдачи заказов СДЭК.
Осуществляется транспортными компаниями. Вы можете заказать доставку в вашем городе и получить заказ на терминале. Города и адреса терминалов можно узнать на сайте транспортной компании или при оформлении заказа.
Можете оплатить доставку наличными при получении заказа, или переводом на карту, или по выставленному счету. Заказы суммой более 30 000 ₽ принимаются по предоплате.
зависимости от веса и объема.
день - далее сроки транспортной компании.
Вы также можете воспользоваться услугами другой транспортной компании по вашему выбору. В стоимость доставки будет входить набор товара с нашего склада и доставка до терминала в вашем городе.
Транспортные компании из числа наших партнеров доставят заказ до порога вашего дома. Также менеджер рассчитает стоимость доставки до вашего адреса и выставит счет (дополнит ваш заказ строкой "Доставка"). Заказы суммой более 30 000 ₽ принимаются по предоплате.
зависимости от веса и объема.
день - далее сроки транспортной компании.
- Наличными курьеру
- Наличными в офисе
- Безналичный перевод
- Электронным платежом
- Наложенный платежом